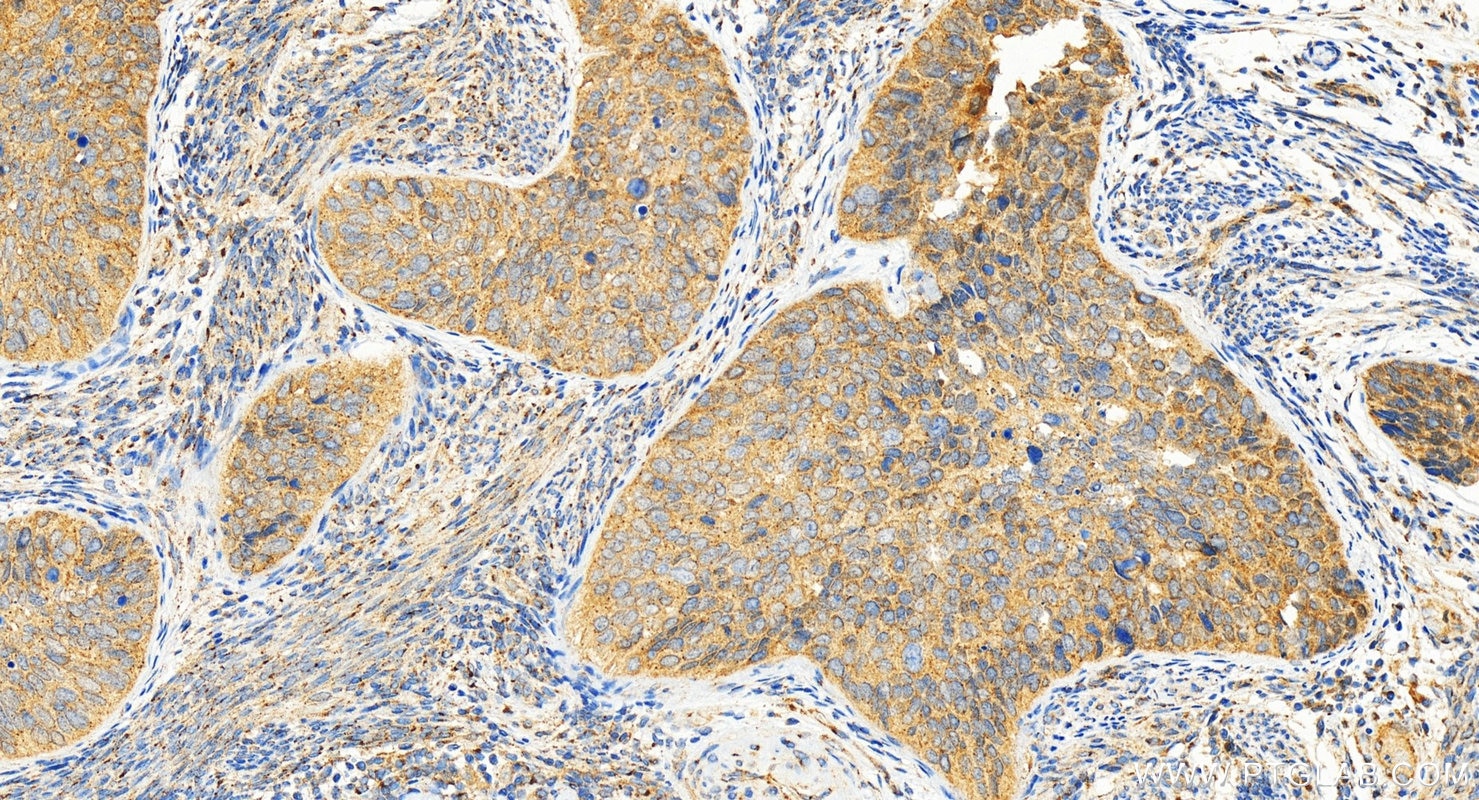
Immunohistochemistry (IHC) staining of human cervical cancer tissue using C12orf30 Polyclonal antibody (31748-1-AP)
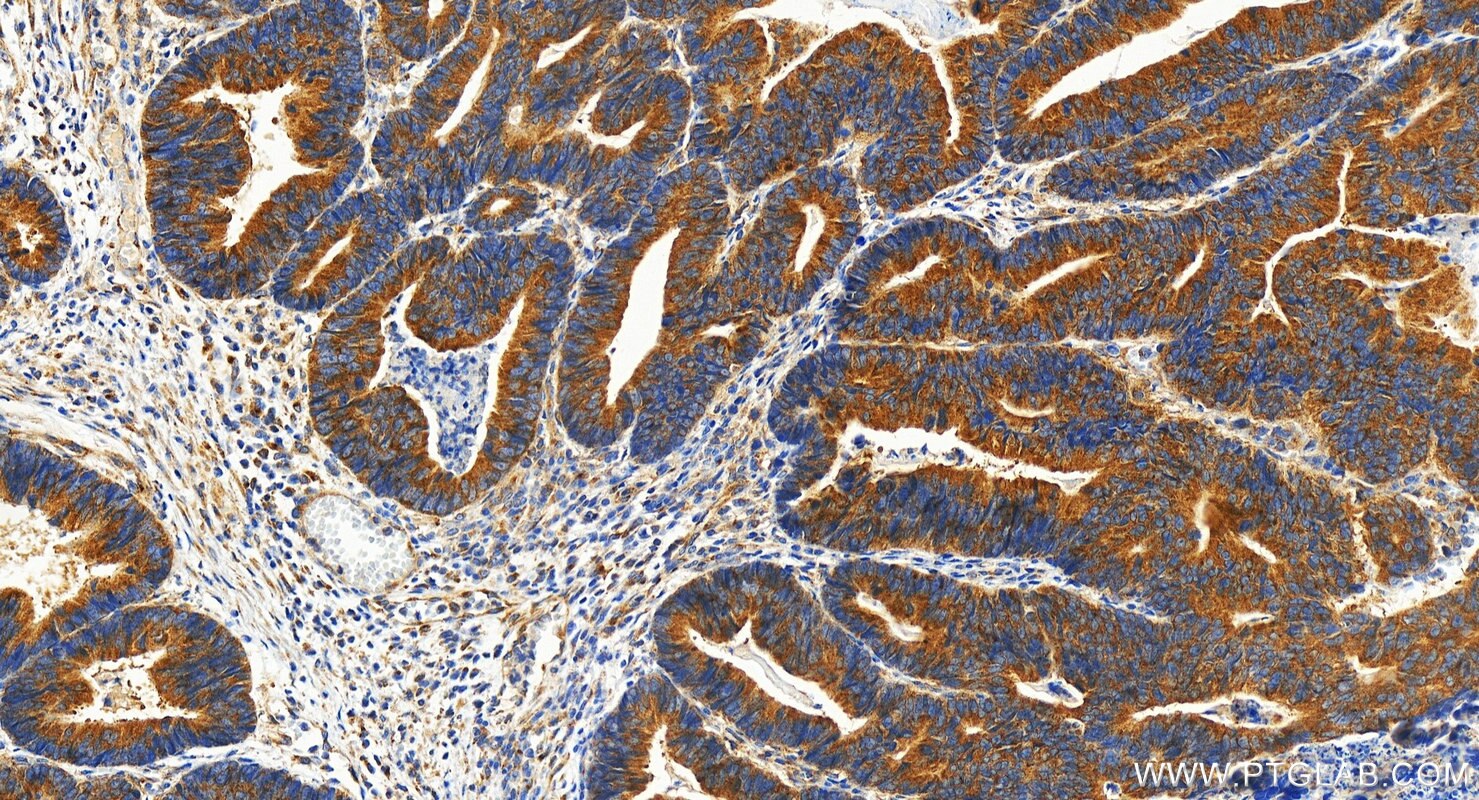
Immunohistochemistry (IHC) staining of human colon cancer tissue using C12orf30 Polyclonal antibody (31748-1-AP)

Tested Applications
| Positive WB detected in | A549 cells, HeLa cells, Calu-1 cells |
| Positive IP detected in | mouse ovary tissue, HeLa cells |
| Positive IHC detected in | human colon cancer tissue, human cervical cancer tissue Note: suggested antigen retrieval with TE buffer pH 9.0; (*) Alternatively, antigen retrieval may be performed with citrate buffer pH 6.0 |
| Positive IF/ICC detected in | A431 cells |
Recommended dilution
| Application | Dilution |
|---|---|
| Western Blot (WB) | WB : 1:5000-1:50000 |
| Immunoprecipitation (IP) | IP : 0.5-4.0 ug for 1.0-3.0 mg of total protein lysate |
| Immunohistochemistry (IHC) | IHC : 1:1000-1:4000 |
| Immunofluorescence (IF)/ICC | IF/ICC : 1:50-1:500 |
| It is recommended that this reagent should be titrated in each testing system to obtain optimal results. | |
| Sample-dependent, Check data in validation data gallery. | |
Product Information
31748-1-AP targets C12orf30 in WB, IHC, IF/ICC, IP, ELISA applications and shows reactivity with human, mouse samples.
| Tested Reactivity | human, mouse |
| Host / Isotype | Rabbit / IgG |
| Class | Polyclonal |
| Type | Antibody |
| Immunogen |
CatNo: Ag36383 Product name: Recombinant human C12orf30 protein Source: e coli.-derived, PGEX-4T Tag: GST Domain: 703-972 aa of BC113585 Sequence: LNHPVEPKNSEKTAENGVSSRIDILRLLLQQLEATLETGKRFIEKDIQYPFLGPVPTRMGGFFNSGCSQCQISSFYLVNDIYELDTSGLEDTMEIQERIENSFKSLLDQLKDVFSKCKGDLLEVKDGNLKTHPTLLENLVFFVETISVILWVSSYCESVLRPYKLNLQKKKKKKKETSIIMPPVFTSFQDYVTGLQTLISNVVDHIKGLETHLIALKLEELILEDTSLSPEERKFSKTVQGKVQSSYLHSLLEMGELLKKRLETTKKLKI Predict reactive species |
| Full Name | chromosome 12 open reading frame 30 |
| Observed Molecular Weight | 113 kDa,140 kDa |
| GenBank Accession Number | BC113585 |
| Gene Symbol | C12orf30 |
| Gene ID (NCBI) | 80018 |
| Conjugate | Unconjugated |
| Form | Liquid |
| Purification Method | Antigen affinity Purification |
| UNIPROT ID | Q14CX7 |
| Storage Buffer | PBS with 0.02% sodium azide and 50% glycerol, pH 7.3. |
| Storage Conditions | Store at -20°C. Stable for one year after shipment. Aliquoting is unnecessary for -20oC storage. 20ul sizes contain 0.1% BSA. |
Background Information
The C12orf30 gene encodes an auxiliary subunit of the N-terminal acetyltransferase B (NatB) complex, which is responsible for the acetylation of methionine residues at the N-terminus of proteins. The C12orf30 protein plays a role in the distribution and morphology of organelles, and is involved in cell migration and the dynamic changes of the cytoskeleton. In addition, polymorphisms in the C12orf30 gene are associated with susceptibility to various autoimmune diseases, such as rheumatoid arthritis, juvenile idiopathic arthritis, and type 1 diabetes. The C12orf30 protein also participates in regulating the function of immune cells, influencing their signal transduction. The theoretical size of C12orf30 protein is 113 kDa, and it is possible that post-translational modifications may have shifted the protein band up to about 140 kD.
Protocols
| Product Specific Protocols | |
|---|---|
| IF protocol for C12orf30 antibody 31748-1-AP | Download protocol |
| IHC protocol for C12orf30 antibody 31748-1-AP | Download protocol |
| IP protocol for C12orf30 antibody 31748-1-AP | Download protocol |
| WB protocol for C12orf30 antibody 31748-1-AP | Download protocol |
| Standard Protocols | |
|---|---|
| Click here to view our Standard Protocols |